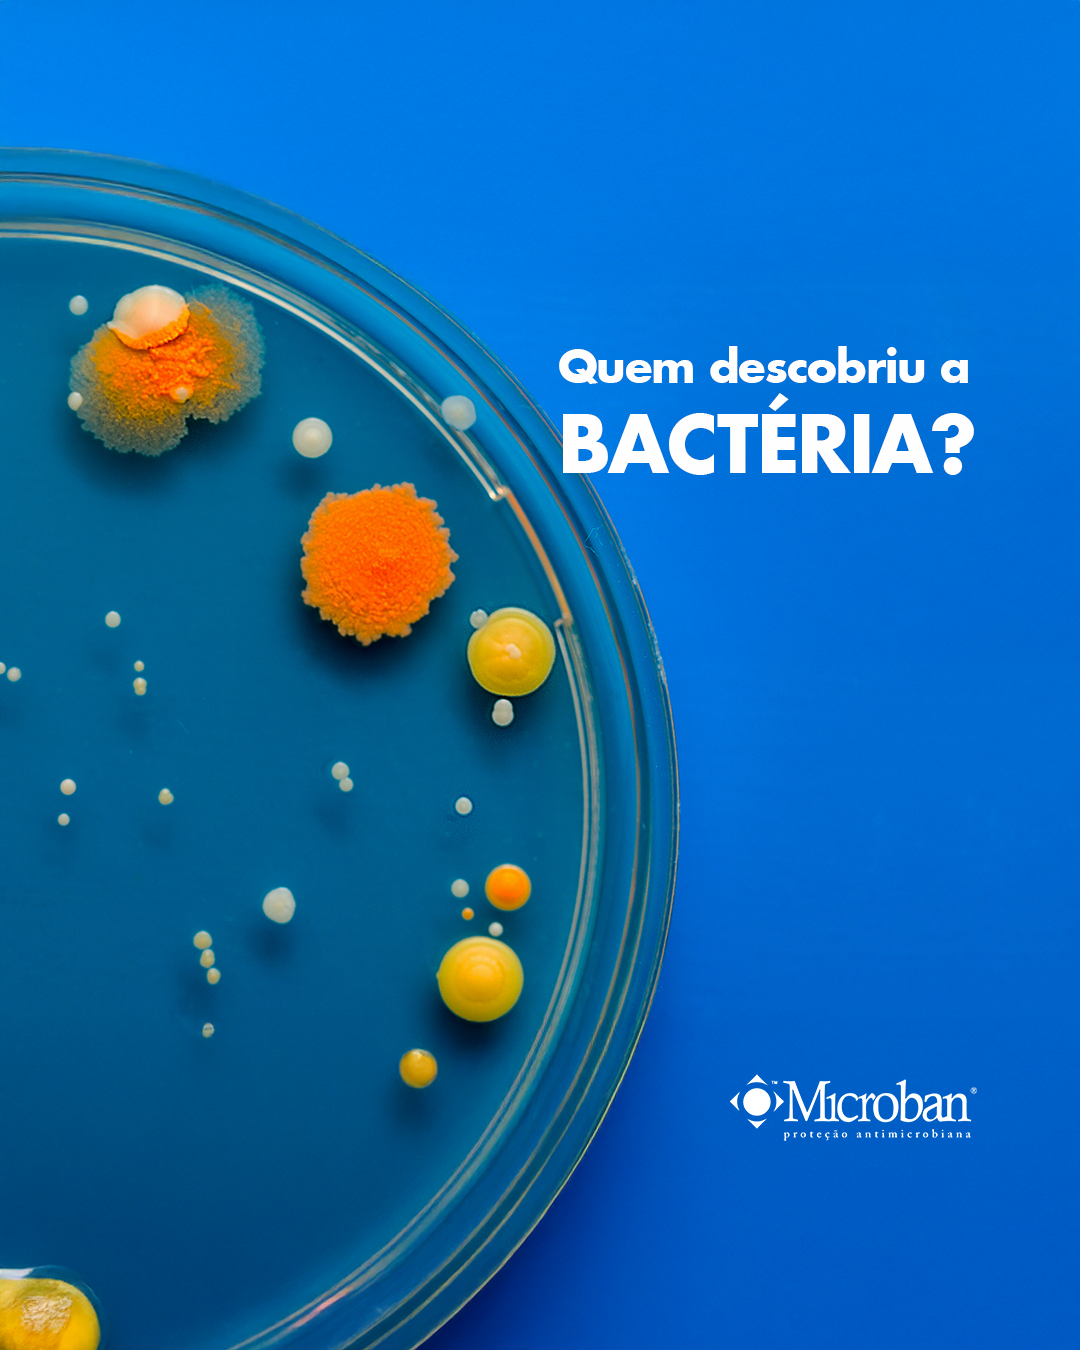
02
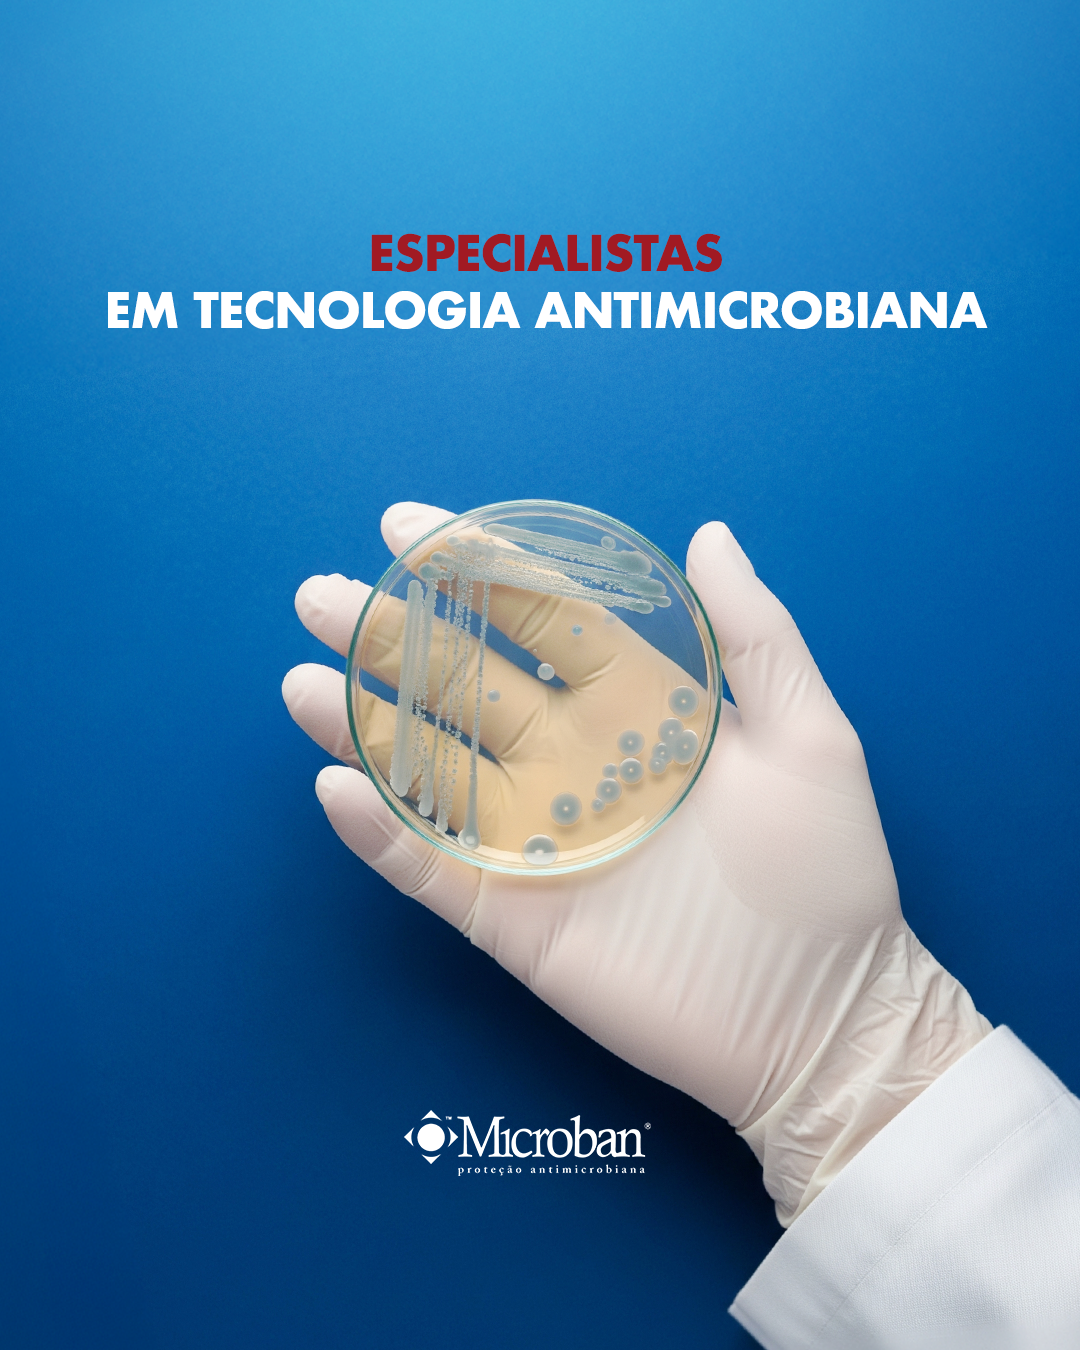
05
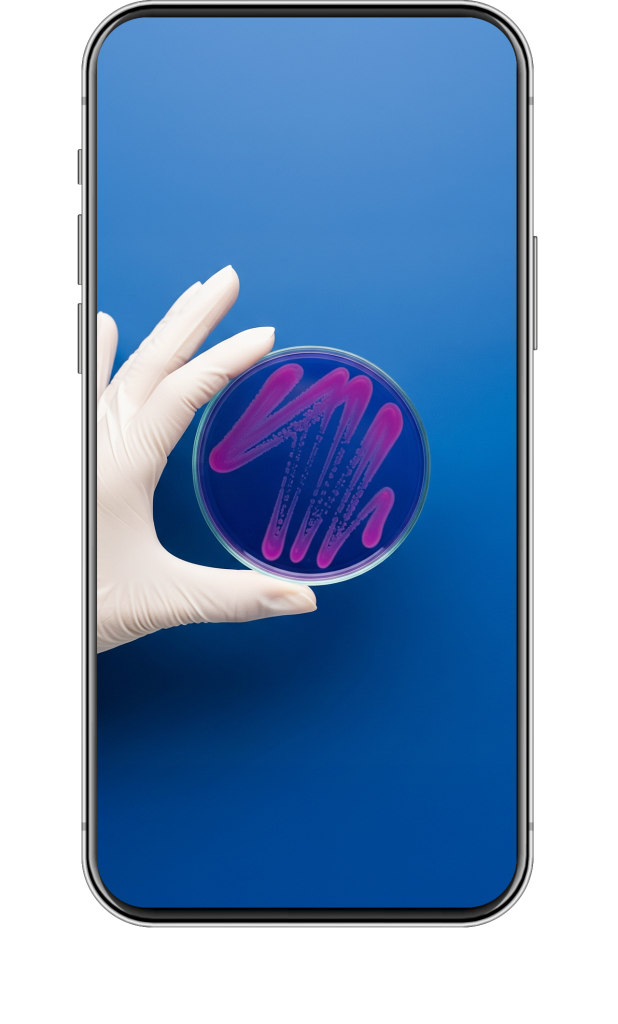

MICROBAN | CAMPANHA DIGITAL
Quando uma estratégia
local inspira o mundo
A Microban é líder global em tecnologias antimicrobianas e de controle de odor. Com presença em mais de 50 países e em bilhões de produtos, de eletrodomésticos a superfícies hospitalares, a marca é referência mundial quando o assunto é proteção invisível. No Brasil, a missão era outra: traduzir toda essa autoridade científica para o digital, com uma presença de marca mais humana, próxima e conectada ao cotidiano.
DESAFIO
A Microban já era uma gigante global, mas sua presença nas redes seguia um modelo técnico, institucional e pouco engajador. Em vez de replicar esse caminho no Brasil, propusemos algo novo: criar uma rede social local, com linguagem mais humana, próxima e conectada ao dia a dia. O desafio era mostrar o valor de uma proteção invisível… de um jeito que todo mundo conseguisse ver.
ESTRATÉGIA
• CONTEÚDO
• META ADS
• GOOGLE
• META ADS
CRIAÇÃO
• IDENTIDADE VISUAL
• CRIATIVOS REDES SOCIAIS
• DISPLAY
• CRIATIVOS REDES SOCIAIS
• DISPLAY
CLIENTE
MICROBAN